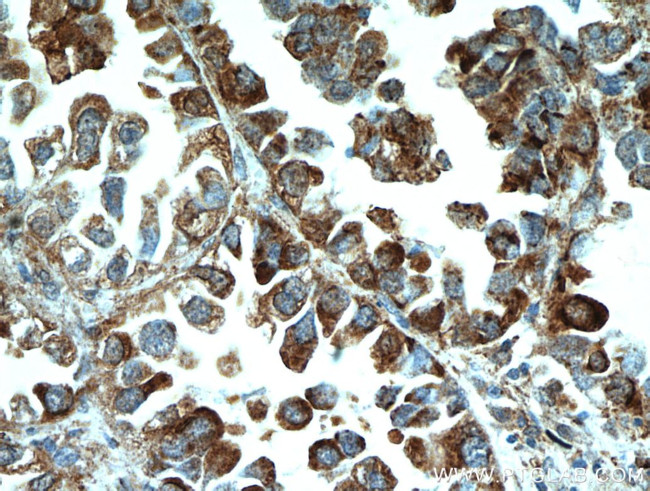
MPP3 Antibody in Immunohistochemistry (Paraffin) (IHC (P))
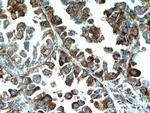
MPP3 Antibody in Immunohistochemistry (Paraffin) (IHC (P))

Search
Proteintech
MPP3 Polyclonal Antibody
{{$productOrderCtrl.translations['antibody.pdp.commerceCard.promotion.promotions']}}
{{$productOrderCtrl.translations['antibody.pdp.commerceCard.promotion.viewpromo']}}
{{$productOrderCtrl.translations['antibody.pdp.commerceCard.promotion.promocode']}}: {{promo.promoCode}} {{promo.promoTitle}} {{promo.promoDescription}}. {{$productOrderCtrl.translations['antibody.pdp.commerceCard.promotion.learnmore']}}
产品信息
14650-1-AP
种属反应
已发表种属
宿主/亚型
分类
类型
抗原
偶联物
形式
浓度
规格
纯化类型
保存液
内含物
保存条件
运输条件
产品详细信息
Immunogen sequence: KESKVFMRA LFHYNPREDR AIPCQEAGLP FQRRQVLEVV SQDDPTWWQA KRVGDTNLRA GLIPSKGFQE RRLSYRRAAG TLPSPQSLRK PPYDQPCDKE TCDCEGYLKG HYVAGLRRSF RLGCRERLGG SQEGKMSSGA ESPELLTYEE VARYQHQPGE RPRLVVLIGS LGARLHELKQ KVVAENPQHF GVAVPHTTRP RKSHEKEGVE YHFVSKQAFE ADLHHNKFLE HGEYKENLYG TSLEAIQAVM AKNKVCLVDV EPEALKQLRT SEFKPYIIFV KPAIQEKRKT PPMSPACEDT AAPFDEQQQE MAASAAFIDR HYGHLVDAVL VKEDLQGAYS QLKVVLEKLS KDTHWVPVSW VR (225-585 aa encoded by BC056865)
靶标信息
This gene product is a member of a family of membrane-associated proteins termed MAGUKs (membrane-associated guanylate kinase homologs). MAGUKs interact with the cytoskeleton and regulate cell proliferation, signaling pathways, and intracellular junctions. This protein contains a conserved sequence, called the SH3 (src homology 3) motif, found in several other proteins that associate with the cytoskeleton and are suspected to play important roles in signal transduction. Alternatively spliced transcript variants have been identified. One transcript variant is experimentally supported, but it doesn't encode a protein.
仅用于科研。不用于诊断过程。未经明确授权不得转售。
生物信息学
蛋白别名: Discs large homolog 3; discs, large homolog 3; human homolog of Drosophila lethal discs large 1; Method: conceptual translation supplied by author.; MAGUK p55 subfamily member 3; MAGUK p55 subfamily member 3 {ECO:0000250|UniProtKB:O88910}; membrane palmitoylated protein 3; membrane protein palmitoylated 3; membrane protein, palmitoylated 3 (MAGUK p55 subfamily member 3); Mpp3 membrane protein, palmitoylated 3; mpp3 {ECO:0000312|RGD:620015}; protein Dlgh3; Protein MPP3; unnamed protein product
基因别名: 6430514B01; CSG18; DLG3; Dlgh3; Dusp3; MPP3
UniProt ID: (Human) Q13368, (Rat) O88954
Entrez Gene ID: (Human) 4356, (Rat) 114202, (Mouse) 13384